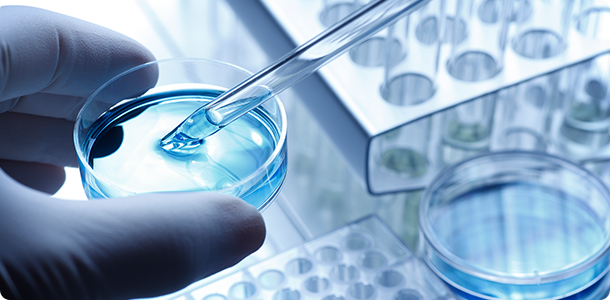
オープンイノベーション

閉じる
食と生活を支える
私たちは、
研究開発型のソリューション企業です。
太陽化学のソリューション
製品を探す
- 素材で探す
- 用途で探す
食と健康Lab
太陽化学の研究と技術
食と健康コラム
- 健康を支える研究と技術
- おいしさを支える研究と技術
- 化粧品・化成品を支える研究と技術
太陽化学のメールマガジン
太陽化学からみなさまへ情報提供のためにお送りしています。
「情報と出会うキッカケ」となれば幸いです。
知ってトクする「技術・製品・提案情報」をお届けします。
お問い合わせ
製品情報、IR、その他のお問い合わせは
下記ページからお願いいたします。